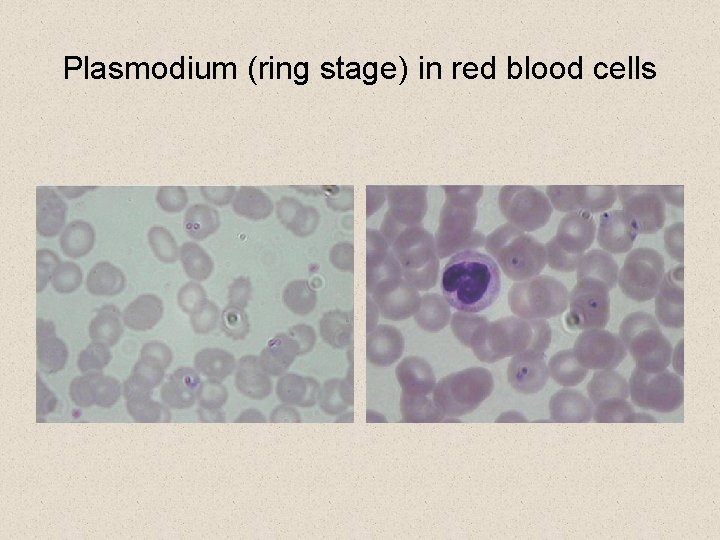

General Biology of Protists the Most Ancient Eukaryotes

General Biology of Protists, the Most Ancient Eukaryotes • protists are eukaryotes united on the basis of a single negative characteristic § they are not fungi, plants, or animals § in all other respects, they are highly variable with no uniting features

A unicellular protist.

General Biology of Protists, the Most Ancient Eukaryotes • cell surface varies among protists § all protists have plasma membranes § some, like algae and molds, have cell walls § others, like diatoms and radiolarians, secrete glassy shells of silica • locomotor organelles also vary among protists § protists move by means of cilia, flagella, pseudopods or gliding mechanisms

General Biology of Protists • cyst formation occurs in protists who, despite having delicate surfaces, persist in harsh habitats § cysts are dormant forms of a cell with a resistant outer covering • in dormancy, the cell metabolism is more or less completely shut down

General Biology of Protists • protists employ a variety of forms of nutritional acquisition § one exception, however, is chemoautotrophy, which is known only from prokaryotes § some protists are photosynthetic autotrophs, called prototrophs § among the heterotrophic protists, there are • phagotrophs that ingest visible particles of food • osmotrophs that ingest food in soluble form

General Biology of Protists, the Most Ancient Eukaryotes • protists typically reproduce asexually § sexual reproduction is resorted only in times of stress • asexual reproduction involves an usual form of mitosis § the nuclear membrane usually persists throughout mitosis and the spindle apparatus forms within the nucleus • asexual reproduction in protists may involve spore formation or fission § the most common type of fission is binary fission, in which a cell simply splits into two nearly equal halves § another type of fission is called budding

General Biology of Protists, the Most Ancient Eukaryotes • asexual reproduction in protists may involve spore formation or fission § the most common type of fission is binary fission, in which a cell simply splits into two nearly equal halves § another type of fission is called budding • In this case, the progeny cell is considerably smaller than its parent and then must grow to adult size § multiple fission is called schizogony and is preceded by several nuclear divisions • this form of fission produces several individuals almost simultaneously

General Biology of Protists, the Most Ancient Eukaryotes • sexual reproduction also takes place in many forms among protists § gametic meiosis occurs in ciliates and some flagellates § zygotic meiosis occurs in the sporozoans § sporic meiosis occurs in the algae, producing an alternation of generations similar to that of plants

General Biology of Protists, the Most Ancient Eukaryotes • being a single-celled organism presents certain problems § size is limited due to surface-to-volume ratio problems • the evolution of multicellularity alleviates the size constraints § a multicellular organism is composed of many cells § having multiple cells allows for specialization • distinct cell types can have different functions • this is a “division of labor”

General Biology of Protists, the Most Ancient Eukaryotes • many protists form colonial assemblies consisting of many cells with little differentiation or integration § a colonial organism is a collection of cells that are permanently associated but in which little or no integration of cell activities occurs

General Biology of Protists, the Most Ancient Eukaryotes • an aggregation is a more transient collection of cells that come together for a period of time and then separate § for example, individual amoeboid cells of cellular slime molds come together to form an aggregate called a slug • the slug allows the aggregrate of slime mold cells to move to a new feeding location as a unit

General Biology of Protists, the Most Ancient Eukaryotes • true multicellularity occurs only in eukaryotes § it requires that the activities of individual cells be coordinated and that the cells be in contact • three groups of protists have independently evolved multicellularity § brown algae (Phylum Phaeophyta) § green algae (Phylum Chlorophya) § red algae (Phylum Rhodophyta) • but not all types of algae are multicelluar; there also unicellular varieties

Classifying the Protists • protists are the most diverse of the four kingdoms in the domain Eukarya § there are 15 distinct phyla of protists § taxonomists group the protists into five general groups according to some of the major shared characteristics § the phyla of protists are, with very few exceptions, only distantly related to one another

The major protist groups.

Classifying the Protists • the characteristics used in broad attempts to classify the kingdom Protista include § § § § § the presence or absence and type of cilia or flagella the presence and kinds of pigments the type of mitosis the kinds of cristae present in the mitochondria the molecular genetics of the ribosomal “S” subunit the kind of inclusions the protists may have overall body form whether the protists has a shell or other “body armour” modes of nutrition and movement

Kinds of Protists

1. Heterotrophs with No Permanent Locomotor Apparatus • the largest of the five groups of protists are distinguished by having no permanent locomotor apparatus • they are all heterotrophic and comprise three phyla § Rhizopoda—amoebas § Foraminifera—forams § Actinopoda—radiolarians

Heterotrophs with No Permanent Locomotor Apparatus • amoebas lack flagella and cell walls • they move using pseudopodia, flowing projections of cytoplasm • • amoebas are abundant in soil and many are parasitic in animals • reproduction is entirely asexual Amoeba

Heterotrophs with No Permanent Locomotor Apparatus • forams possess rigid cells and move by cytoplasmic streaming • they are marine protists with pore-studded shells called tests • long, thin, cytoplasmic projections called podia radiate through the test pores and are used for swimming and capturing prey Figure 20. 9 A foram.

Heterotrophs with No Permanent Locomotor Apparatus • radiolarians look like amoebas but have a glassy skeleton • needlelike pseudopods look like thorns radiating out from the body Figure 20. 10 A radiolarian.

2. Heterotrophs with Flagella • Sarcomastigophora is a strictly heterotrophic phylum • the members of this phylum are called zoomastigotes and are flagellated • the flagellated ancestor of all animals appears to have been a member of this group Zoomastigotes cause sleeping sickness.

Trypanosoma gambiens

Trichomonas vaginalis

2. Heterotrophs with Flagella • ciliates belong to the phylum Ciliophora and all members possess large numbers of cilia • ciliates have a defined cell shape and two nuclei per cell • the pellicle is a proteinaceous scaffold, found inside the plasma membrane, that confers flexible support • asexual reproduction is by fission while sexual reproduction is by conjugation A ciliate.

Transverse division in paramecium

Conjugation in Paramecium

4. Photosynthetic protists • dinoflagellates are members of the phylum Pyrrhophyta • they are photosynthetic unicellular protists, usually bearing two flagella of unequal length § These flagella beat uniquely, beating the body like a spinning top

Dinoflagellates.

• some dinoflagellates produce powerful toxins § “red tides” are population explosions of these kinds of dinoflagellates Red tide.

Photosynthetic Protists • euglenoids belong to the phylum Euglenophyta and have two flagella § about one-third are photosynthetic and have chloroplasts § the remaining types lack chloroplasts and are heterotrophic § the photosynthetic forms can become heterotrophic when light levels are low

Photosynthetic Protists • Euglena is a representative euglenoid • it possesses a pellicle like ciliates • it has a contracticle vacuole to help regulate the osmotic pressure within the organism • it has a light-sensitive stigma which helps this photosynthetic form find light • reproduction in this group is entirely asexual A euglenoid.

Photosynthetic Protists • diatoms are photosynthetic protists that belong to the phylum Chrysophyta Diatoms. • they are encased by unique double wall of silica • they reproduce by either asexual or sexual reproduction Fossilized deposits of diatom shells are mined as “diatomaceous earth. ”

Diatoms

Diatoms

Diatoms

Photosynthetic Protists • the phylum Chrysophyta, in addition to diatoms, also includes the golden algae • the golden algae do not resemble three phyla of true algae in any important aspect • they are named because pigments in their chloroplasts give them a golden color • they can be unicellular or colonial and occur in freshwater only • they can form resistant cysts when ponds and lakes dry out in summer

Photosynthetic Protists • View complex algae PP in my Website

5. Nonmotile Spore-Formers • sporozoans belong to the phylum Apicomplexa • they are nonmotile, unicellular, parasites that form spores • they cause many diseases in humans and domestic animals. Example: Plasmodium the cause of malaria • they have complex life cycles that involve both asexual and sexual phases, often involving an alternation between different hosts
Plasmodium (ring stage) in red blood cells

A sporozoan (plasmodium) life cycle.
- Slides: 40